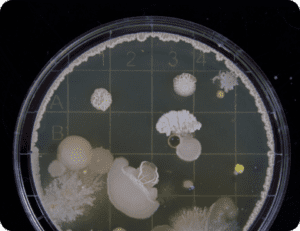

Collection: Air Purifier
What makes Ozoneair Purify™ so effective? It’s our Oxyplasma® technology.
This unique method targets tiny particles and eliminates gases that are 1000 times smaller
than what standard HEPA filters can capture.
This groundbreaking technology is at the heart of Ozoneair Purify™’s outstanding air purification performance.
-
Ozoneair Purify 30
Regular price Rp 8.999.000,00 IDRRegular priceUnit price / per -
Ozoneair Purify 60
Regular price Rp 11.999.000,00 IDRRegular priceUnit price / per -
Ozoneair Purify 150
Regular price Rp 14.999.000,00 IDRRegular priceUnit price / per
-

Smoke
Purify effectively reduces smoke from cigarettes and stoves, leading to cleaner air in the home.
-

Mold
By eliminating mold spores, Purify contributes to less odor and a fresher indoor environment.
-

Bad smell
Purify removes unpleasant odors, creating a more pleasant atmosphere in your home.
-

Poor indoor air quality
Purify improves air quality by filtering out particles and gases, promoting a better indoor environment.
-

VOC
By neutralizing everyday gases, Purify helps protect and improve air quality.
-

Allergens
Purify reduces the presence of allergens such as pollen and pet dander, contributing to cleaner indoor air.